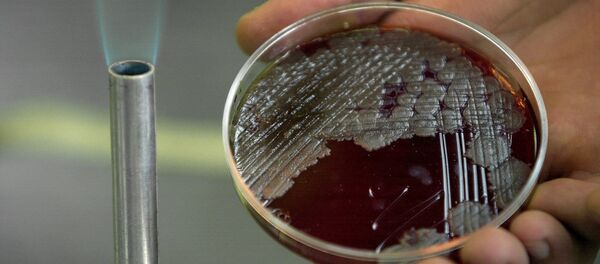
Şarbon bakterisi - Sputnik Türkiye

Kurban Bayramı'yla beraber Ankara, Kocaeli, İstanbul, Kayseri gibi pek çok kentte şarbon karantinaları uygulanmıştı. Eski gıda, tarım ve hayvancılık bakanı Ahmet Eşref Fakıbaba ise ‘et fiyatlarını artırmak isteyen fırsatçı lobiler' tarafından olayın büyütüldüğünü savunmuştu.
Hürriyet'te yer alan habere göre TTB'de düzenlenen basın toplantısında sağlık meslek örgütlerince hazırlanan ortak metin paylaşıldı.
28 Nisan 2018 tarihli bir düzenlemeyle ithal edilen hayvanların sağlık denetimlerinde veteriner hekim zorunluluğunun kaldırıldığını ve ziraat mühendisi, orman mühendisi, kimya mühendislerine de yetki verildiğini belirten meslek örgütleri şu ifadeleri kullandı:
"Böylelikle hastalığı tanıyan meslek grupları veteriner hekimler ve zooteknistler denetimden uzaklaştırılmıştır. Bu değişiklik öncesinde yapılan ‘ithal edilecek hayvanların, ihracatçı ülkede bakanlık çalışanı veteriner hekimlerin kontrolünden geçmeleri, sınır bölgelerinde veteriner kontrolünde kurulan karantina bölgelerinde tutularak olası bir hastalığın ortaya çıkması ve hayvana mikrop bulaşmış ise hastalığın ortaya çıkması için gereken 21 günlük kuluçka süresinin tamamlanması ve ülkeye girmeden önce de laboratuvar tetkiklerinin tekrarlanması işlemlerinin' artık yapılmayacağı anlaşılmaktadır."